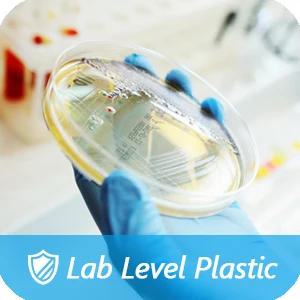

Share on (1600844968210):
Product Name | petridish lab supplies sterile plastic dish organizer plant cell tissue culture lab placas petri plate petri dish petri |
Place Of Origin | Dongguan/ Shenzhen |
Craft | Injection Molding |
Colour | clear/Customized |
Shape | Tubular |
Size | 35mm/60mm/100mm etc(Customized) |
Material | PP material/other can Customized |
Multifunction | Great for laboratory analysis,school science project, scientific research, seed cultivation, mycology studies, etc. |
Feature | These petri dishes are optically clear for good clarity in microscopic examination. The petri dishes have a flat growth surface for uniform cell growth without clumping. |
Related freight | Online prices are for reference only, Related specifications freight,please contact customer service quotation |
Related specifications | Online price for reference only, specific specifications of the product price please contact customer service, thank you very much |
warm prompt | If need Petri Dish mold, we also can sell, details contact us |

New products from manufacturers at wholesale prices